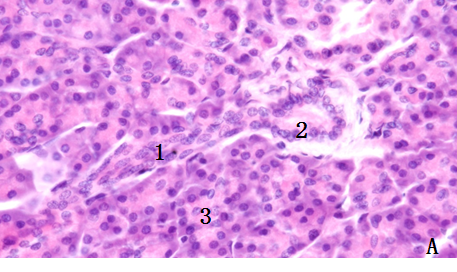

胰腺
胰腺(pancreas):是人体内起主要消化作用的消化腺,胰腺表面覆有薄层结缔组织被膜,结缔组织伸入腺内将实质分为许多小叶,腺实质由外分泌部和内分泌部组成。

胰腺 ( HE染色 →胰岛)
(一) 外分泌部
胰腺外分泌部占胰腺的大部分,为复管泡状浆液腺。
1. 腺泡:每个腺泡由40~50个锥体形腺细胞构成,腺细胞与基膜之间无肌上皮细胞。腺腔内有一些扁平或立方形细胞称泡心细胞(centroacinar cell),是延伸入腔内的闰管起始部上皮细胞。泡心细胞较小,胞质染色浅,核圆形。胰腺腺泡分泌多种消化酶,腺细胞还分泌一种胰蛋白的抑制因子,可阻止胰蛋白酶原在胰腺内激活,防止胰腺自溶。

1.闰管 ;2.小叶内导管; 3.浆液性腺泡
2. 导管:闰管较长,起于泡心细胞,管径细,汇合形成小叶内导管。小叶内导管由单层立方上皮构成,出小叶后移行为由单层柱状上皮构成的小叶间导管。主导管由小叶间导管汇合而成,由单层高柱状上皮和少量杯状细胞构成。胰腺导管上皮分泌的水和电解质与腺泡分泌的消化酶共同组成胰液。


黄色。B细胞分泌胰岛素(insulin),胰岛素能促进糖原的合成,降低血糖。胰岛素缺乏时,糖原的合成发生障碍,导致血糖浓度增高,并随尿排出,临床上称为糖尿病。
3. D细胞:约占胰岛细胞总数的5%左右,散在于A、B细胞之间,Mallory染色胞质呈蓝色,电镜下胞质内含较大的分泌颗粒。D细胞分泌生长抑素,抑制A、B细胞的分泌活动。
4.PP细胞:细胞数量
蓝色箭头:闰管 ;黄色箭头:小叶内导管;D:小叶间导管
(二) 内分泌部
胰腺的内分泌部即胰岛(pancreatic islet),为分散在外分泌部之间的大小不等、形状不规则的细胞团,HE染色浅。胰岛细胞之间有丰富的毛细血管。胰岛主要有A、B、D、PP四种细胞。

黑色箭头示胰岛;1.腺泡;2.小叶内导管
1. A细胞:约占胰岛细胞总数的20%左右,细胞体积较大,多分布于胰岛周边,Mallory染色胞质呈鲜红色。A细胞分泌胰高血糖素,可使糖原分解,血糖升高。
2. B细胞:占胰岛细胞总数的70%,细胞较小,多分布于胰岛中央,分泌胰岛素,促进肝细胞、脂肪细胞、肌细胞等将血液中的葡萄糖吸收并转化为糖原或脂肪贮存,使血糖降低。
3.D细胞:分布于A细胞和B细胞之间,与其有缝隙连接,分泌生长抑素,抑制它们的分泌活动。
4.PP细胞:数量很少,于胰岛周边,分泌胰多肽,抑制胃肠运动、胰液分泌及胆囊收缩。

胰岛光镜图
免疫组织化学染色(辣根过氧化物酶标记)示B细胞含胰岛素,呈棕黑色)


